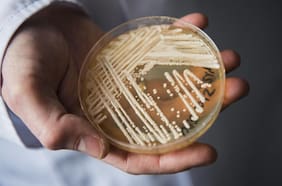

Propagación
25 MARZO
07 DICIEMBRE
28 ABRIL
La alerta fue dada por la Organización Mundial de Salud (OMS) tras una nueva epidemia de esta fiebre hemorrágica en el noroeste de la República Democrática del Congo. La reaparición de este virus en la ciudad de Mbandaka ha causado dos muertos desde el 21 de abril. A la fecha, “267 contactos han sido identificados”, según la OMS, que juzga “difícil de evaluar la envergadura de la epidemia”.
OMS no descarta propagación regional e internacional de virus del ébola desde África
01 FEBRERO
Justo cuando los casos de Covid-19 causados por la variante Delta venían a la baja en nuestro país, comenzó la circulación de Ómicron, la variante más contagiosa conocida hasta ahora. En el mundo es también la dominante pero sigue conviviendo con Delta que aún no se ha ido y sigue generando casos graves.
¿Dónde está Delta? Pese al avance de la variante Ómicron, no ha desaparecido y sigue causando cuadros graves de Covid-19
31 ENERO
13 ENERO
16 DICIEMBRE
“La única protección real es recibir la inyección”, dijo el mandatario estounidense y pronosticó “un invierno de enfermedad grave y muerte” para los no vacunados. EE.UU., el país más afectado del mundo por la pandemia, actualmente tiene un promedio de 1.150 muertes diarias por Covid-19, según cifras de los Centros para el Control y la Prevención de Enfermedades (CDC).
Presidente Biden advierte que Ómicron “se va a propagar mucho más rápidamente” en Estados Unidos
29 NOVIEMBRE
17 NOVIEMBRE
Según la OMS, Delta representa el 99,5% de todas las secuencias genómicas informadas en las bases de datos públicas y ha “superado” a otras variantes en la mayoría de los países. Dada su globalidad, muchos expertos creen ahora que todas las variantes futuras serán ramificaciones de Delta.
“Superpotente transmisibilidad”: Variante Delta ya representa el 99% de los casos del mundo e infectados portan 1.200 veces más virus que versión original del coronavirus
23 JUNIO
01 JUNIO
01 MARZO
Un estudio realizado por la Universidad de Aoyama Gakuin en Japón encontró que el uso de tapabocas no sería suficiente para evitar la propagación del virus, encendiendo las alarmas ante la apertura de distintos servicios de atención al cliente.
Simplemente hablar mientras estás infectado puede transmitir Covid-19, incluso mientras usas mascarillas
Lo más leído
1.
2.
3.
4.
5.
Casi nadie tiene claro qué es un modelo generativo. El resto lo leyó en La Tercera
Plan Digital + LT Beneficios$6.990 al mes SUSCRÍBETE